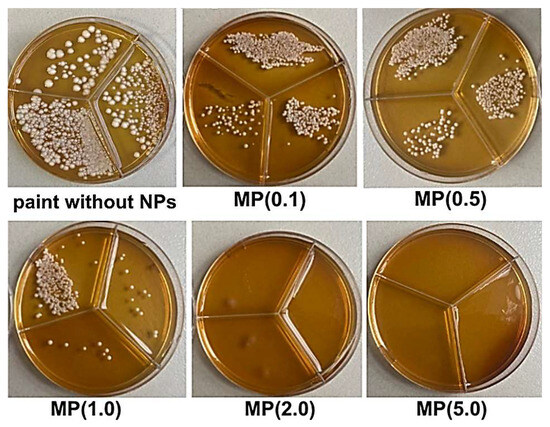

Abstract
Today, one of the biggest challenges is infections in the painted walls of hospitals. Acrylic-based paints are a target of antibiotic-resistant microorganisms since they contain cellulosic compounds as thickeners. The aim of this study was to synthesize and investigate the biocidal activity and toxicity of heterophase ZnO-Ag nanoparticles fixed in water-based acrylic paint layers in reference to a nontreated water-based paint. The ZnO-Ag nanoparticles with average particle sizes of about 80 nm were simply obtained by electrical explosion of two twisted wires in an oxygen-containing atmosphere. The nanoparticles and modified paint were characterized using SEM, TEM, XPS, and XRD techniques. The antimicrobial activity of the nanoparticles and modified paint layers was tested against P. aeruginosa, S. aureus, MRSA, E. coli bacteria, and C. albicans using ISO 22196. The antiviral activity against smallpox virus was tested according to ISO 21702. Flow cytometry tests were used to investigate the toxicity of the modified paint coating. As-synthesized nanoparticles had “Janus-like” morphology, with a clear interface inside the nanoparticle. Nanoparticles had enhanced antibacterial activity, which is based on the nanoparticle photocatalytic activity in water decomposition and reactive oxygen species generation. The paint coating with a ZnO-Ag nanoparticle mass ratio of 1.0 wt.% displayed significant antibacterial activity (more than a 99% reduction) and 100% antifungal activity. In addition, this coating inactivates >99% of the virus after 2 h of contact relative to a nontreated control paint. The paint coating showed low toxicity against the sensitive 3T3 fibroblast cell line. More than 90% cell viability was observed after 24 h of incubation with the sample extract. Therefore, heterophase ZnO-Ag nanoparticles have high biocidal activity and low toxicity use and can be applied to other commercial water-based paints to improve their performance against pathogens.
1. Introduction
Currently, the spread of nosocomial infections is still a pressing issue despite the rapid development of medical science and technology [1]. Antimicrobial resistance (AMR) is expected to become the leading cause of death in the world in the coming decades [2]. This has certainly been fueled by the SARS-COV19 coronavirus pandemic, the effects of which are still ongoing [3]. In response to the propagation of AMR in recent decades, there has been an increasing demand for new materials with antimicrobial and virucidal properties [4].
Against this background, special antimicrobial paints that act as a barrier against pathogens are of great interest [5]. The majority of research has focused on the modification of water-based coatings that contain cellulose-based additives as thickeners. The presence of cellulose promotes the growth of bacteria and fungi that use cellulose as a nutrient source [6]. Due to the low chemical solvent resistance of antibiotics, metal nanoparticles and metalloantibiotics have relatively recently been promoted as potential antimicrobial agents for cellulose modification [7]. The addition of nanoparticles to water-based emulsion paints allows us to obtain so-called smart paints for anticorrosive and antimicrobial applications [8]. The antimicrobial activity of smart paints is provided mainly by the photocatalytic activity of nanoparticles and their ability to generate reactive oxygen species [9,10]. The decomposition of contaminants, including cell membranes of bacteria and viruses, under the action of reactive oxygen species improves the quality and appearance of painted surfaces [11,12].
The most promising materials for such purposes are zinc oxide-based nanoparticles. Zinc oxide (ZnO) is an n-type semiconductor, characterized by low toxicity, high chemical stability, enhanced photoelectronic properties, a wide range of antimicrobial activity, and low cost [13,14]. ZnO has been reported as a constituent of virucidal agents [15,16,17,18,19]. In addition, ZnO has been listed as “Generally Recognised as Safe” by the Food and Drug Administration due to its nontoxic properties [20]. The great advantage of ZnO over other wide-bandgap semiconductors, such as TiO2, is that ZnO absorbs electromagnetic radiation in the UV and visible region [21]. The doping of ZnO with noble metals can provide very strong antibacterial activity comparable to modern antibiotics [22]. The doping of zinc oxide with silver has been proven to enhance antimicrobial activity against a wide range of microorganisms [23,24,25,26].
Usually, the chemical co-precipitation method is used to obtain heterophase ZnO-Ag NPs. However, the application of such NPs is limited by the presence of impurities of chemical reagents at the interface of the particle. This reduces NP antimicrobial activity and increases toxicity. In the present study, ZnO-Ag NPs were produced in one step by the simultaneous electrical explosion of silver and zinc twisted wires (EETWs) in an oxygen-containing atmosphere. The EETWs process is a simple, highly productive, and inexpensive nanoparticle fabrication method which can be easily adapted to different applications. The EETWs method takes place in a gas environment. Only argon and oxygen are present during synthesis. The obtained heterophase ZnO-Ag NPs with an optimal range of silver toxicity concentration were fixed in water-based acrylic paint layers. The physicochemical and photocatalytic properties of the NPs, as well as the structural, antiviral, antibacterial, and antifungal characteristics of NP-modified paint coating, were investigated. The results showed that the nanoparticle-modified paint coating has antiviral, antibacterial, and self-cleaning properties and may have significant potential for use as protective coatings.
2. Materials and Methods
2.1. Preparation of ZnO-Ag NPs
To obtain ZnO-Ag nanoparticles (NPs), the electrical explosion of twisted wires (EETWs) of silver and zinc in an argon/oxygen mixture was used on the UDP-2 assembly (Advanced Powder Technology, Russia). The application of the EETWs method for the preparation of heterophase NPs has been described in detail previously [27]. The advantages of EETWs technology are its environmental friendliness and high throughput of about 200 g/h. A schematic diagram of nanoparticle production is shown in Figure 1.

Figure 1.
Scheme of ZnO-Ag NPs preparation: (a) image of twisted wires; (b) photo of EETWs setup; (c) photo of ZnO-Ag nanopowder.
Briefly, a high-density current pulse was applied to twisted zinc and silver wires. The wires explosively fractured, and NPs were formed. Upon synthesis, the NPs were passivated by a slow infusion of air oxygen. The EETWs process parameters for the preparation of ZnO-Ag NPs are summarized in Table 1. The parameters of the electrical explosion of wires were chosen on the basis of preliminary experimental studies. The diameter of silver wire was 0.15 × 10−3 m, and that of zinc wire was 0.38 × 10−3 m. The metal wires were pretwisted between each other. The mass ratio of silver in the nanoparticles was 15%. The silver and zinc mass fractions in NPs depended on the diameter of the silver and zinc wires. The minimum diameter of manufacturing silver wire was 0.15 × 10−3 m.

Table 1.
The parameters for the preparation of ZnO-Ag NPs: d—wire diameter, l—wire length, N—metal ratio, U0—capacitor bank voltage, C—capacitor bank capacity.
A constant gas pressure of 105 Pa was maintained during the EETWs process. The energy input into the wires, in relation to the sublimation energy of the dispersed metals Es, was E/Es = 1.5. The oxygen content in the argon/oxygen medium was 20%vol. and was selected experimentally. At this oxygen content, no combustion of the polymer insulation of the explosion chamber was observed. As experimental studies of the chemical composition of NPs showed, such an argon/oxygen ratio was sufficient for the complete oxidation of metal NPs. For example, when the electrical explosion of zinc wire was performed, metallic Zn was not detected in the nanoparticles prepared. To maintain the composition of the gas mixture, pressure was constantly monitored.
2.2. Preparation of Modified Paint Coating
Water-based acrylic paint (Table 2) was used to obtain the modified coating in the experiments (manufactured by Joint stock company “Association Paints of Yaroslavl”, Yaroslavl, Russia).

Table 2.
The water-based acrylic paint technical information.
The stable water NP suspension was obtained for better dispersion NPs in the water-based acrylic paint matrix. In this study, polyvinylpyrrolidone (PVP) with a molecular weight of 900,000–1,500,000 Dalton was used for the surface modification of ZnO-Ag NPs. For the surface modification of ZnO-Ag NPs, 10 g of nanopowder was dispersed in 90 mL of distilled water. To this dispersion, 1 mL PVP was added under stirring conditions. Then, the NPs-PVP mixture was sonicated for 12 min to disperse and distribute NPs uniformly in the water solution.
The water-based acrylic paint matrix and NPs-PVP mixture were added to the high-speed mixer Wise Tis HG-15D and stirred at 2000 rpm for 1 h, filtered with a sieve (1 μm), and allowed to cool at room temperature. The results obtained are modified paint with various ZnO-Ag NP contents, referred to as the MP sample (Table 3).

Table 3.
Sample description.
The paint formulation ensured the uniform distribution of heterophase NPs in the base volume and prevented their aggregation.
2.3. Characterization
Transmission electron microscopy (TEM, JEM 100 CX II, JEOL, Tokyo, Japan) and scanning electron microscopy (SEM, LEO EVO 50, Zeiss, Germany) were used to characterize the morphology and size distribution of the nanoparticles under study. The average size of NPs and NP agglomerates was determined using CPS DS24000 disk centrifuge (CPS Instruments, Prairieville, LA, USA). The surface composition was investigated by X-ray photoelectron spectroscopy (SPECS Surface Nano Analysis GmbH, Jena, Germany). The phase composition was studied using the XRD-6000 X-ray diffractometer (Shimadzu, Kyoto, Japan) in 2θ ranging from 20 to 80° with CuKα radiation using the Crystal Impact database. A high-speed dispersion mixer was applied for mixing the paint ingredients. An ultrasonic disperser, namely Hilscher UP-100M (30 kHz, Hilscher UP-100M, Hattersheim am Main, Germany), was used for dispersing NPs in water. The shaking of the NP samples was performed using the orbital shaker Biosan PSU-20i (Biosan, Riga, Latvia). The incubation of microorganisms and viruses was performed in an incubator Binder BD53 (Binder, Holzgerlingen, Germany) and a CO2 incubator MSO-20A/C (Sanyo, Tokyo, Japan). To prepare the NP-modified paint samples for electron microscopy, 5 mL samples were preprocessed using an ultrasonic bath and high-shear-rate homogenizer Wise Tis HG-15D. A 10 µL sample was applied with a pipette onto an electron microscopy grid. The grid was then placed on filter paper, followed by drying for 16 h at 25 °C. Coating surface roughness was evaluated by atomic force microscopy (C3M Solver HV, Voronezh, Russia).
In a typical one of these dye degradation experiments, 0.025 g of ZnO-Ag NPs was added to 50 mL of the model organic pollutants, methylene blue (MB) and Congo red (CR), with a concentration of 5 mg/L, and then they were sonicated for 15 min. All solutions were stirred in darkness for 40 min to achieve adsorption–desorption equilibrium between the pollutant solution and NPs. After reaching equilibrium, the suspension was irradiated with visible light using an LED lamp with λ = 500–520 nm, 10 cm away from the reactor with suspension. For every 10 min, 4 mL of the solution was taken. The collected solution was centrifuged at 3500 rpm for 10 min to extract NPs from the solution. Pollutant absorbance decreased gradually at λmax after fixed time intervals, which demonstrated the degree of dye degradation. The optical density of the solution was measured using the UV–vis spectrometer SF-2000 (OKB Spectr, Sankt-Petersburg, Russia) at ambient temperature, with the optical path length of the cuvette being 10 mm. The concentration of the pollutants was determined using linear calibration plots.
2.4. Antibacterial, Antifungal, and Antiviral Activity of Modified Paint Coating
ISO 21702 [28] and ISO 22196 [29] standards were used to determine the biocidal activity of the coatings.
As test surfaces for the study of the antibacterial, antifungal, and antiviral activity of the objects under study, smooth wooden surfaces of 5 × 5 cm made of unpainted hardwood lumber were used. The test surfaces were resistant to the objects under study, did not have any antimicrobial properties of their own, and complied with the national and interstate standards. Test surfaces were selected before the examination in a quantity sufficient for the studies and to ensure their statistical significance (at least three surfaces for each type of research object). The test surfaces were mechanically cleaned, washed with soap and water, brushed, and dried to a constant mass at a temperature of 100 °C. After that, the test surfaces were double-painted with the samples under study and kept until the complete drying and cure of the paint layer. We used 0.35 mL of paint per layer and 0.7 mL of paint for each sample.
A photographic image of the test surface for the study is shown in Figure 2.

Figure 2.
Photograph of a typical test surface prepared for the study before (a) and after (b) modified paint treatment (0.5% NPs).
Paint which was not modified with NPs was used as a negative control.
The following test microorganisms were used to study the antibacterial activity of the objects: Staphylococcus aureus (strain ATCC No. 6538-P); methicillin-resistant S. aureus MRSA (strain ATCC No. 43300); Escherichia coli (strain ATCC No. 25922); and Pseudomonas aeruginosa (strain ATCC No. 27853). In the examination of antifungal (fungicidal) activity, Candida albicans (hospital strain No. 245), a typical representative of the candidiasis pathogens, was used as the test microorganism. Pure microorganism cultures were grown overnight and then adjusted with Mueller–Hinton broth (MHB) (Merck, Kenilworth New Jersey, USA) for bacteria and Sabouraud Dextrose Broth (Himedia labs, Maharashtra, India) was used for C. albicans to a concentration of 1 × 108 CFU/mL using the 0.5 McFarland standard. The microbial suspension was diluted with broth to obtain a bacterial concentration of 6 × 105 CFU/mL (test inoculum).
For the examination of antibacterial and antifungal activity, 0.4 mL of test inoculum was applied on the painted test surfaces using a mechanical pipette with a sterile tip, and this was carefully distributed on the surface using a sterile spatula. The test inoculum was covered with a piece of polypropylene film (40 mm × 40 mm) and exposed for 6 h. After exposure time was completed, the samples were placed in sterile containers containing 10 mL of neutralizer and were shaken for 10 min. Sterile sodium chloride 0.9 wt.% solution was used as a neutralizer. The flush fluid was seeded onto nutrient-dense media and incubated at temperatures of 37 °C and 32 °C for 24 h and 48 h of exposure time for bacteria and C. albicans, respectively, at visible light irradiation. Activity was evaluated by calculating the percentage of the reduction in the microbial contamination of the experimental sample compared to the control coating.
Viruses were grown on the culture of kidney cells of the African green monkey kidney cell line CV-1. The cells were cultured using DMEM/F-12 (1:1) nutrient medium (Biolot, St Petersburg, Russia) containing 10% fetal bovine serum (FBS) (HiClone, Logan, UT, USA). Cells were infected with the virus at a concentration of 0.1–1.0 CFU/cell and incubated for 48 h at 37 °C until full cytopathic action was achieved, and then the virus cells were resuspended in 0.9% NaCl (Biolot, St Petersburg, Russia). To study the antiviral activity of the samples, virus-containing material was used, and the specific activity of SOP s.04 according to the data sheet was (4.5 ± 0.9) × 108 PFU/mL. The virus-containing liquid (0.2 mL) was applied to each test surface. The samples were incubated at 37 °C and 100% relative humidity for 2 h in a CO2 incubator. Incubation time was determined by the viability of the virus on the surface. After the time elapsed, viruses were extracted from the test surface by washing in 20 mL of solvent with complete immersion and shaking at room temperature for 15 min. The washing fluids of each sample were transferred into 96-well plate with cells according to the scheme of serial dilution (Table 4). Plates were infected for 96 h at 37 °C and 5% CO2. Viral viability was assessed by analyzing cell viability using microscopy. The virus-infected cell cultures were compared with control cells. Any differences were evaluated as a cytopathic effect. Next, it was determined in which dilution the virus showed a cytotoxic effect on 50% of cells. The virus titer was calculated according to the method of Reed and Mench.

Table 4.
Schematic of the virus titer assay 96-well plate.
The result was estimated by viral clearance, and the maximum decrease in the infecting viral dose in the experiment was compared to the control and expressed in decimal logarithms.
2.5. Cytotoxicity of Modified Paint Coating
The flow cytometry test was used to investigate the toxicity of paint coating. The mouse embryonic fibroblast cell line NIH/3T3 was used. This cell line is sensitive to exogenous intoxication. Cells were precultured at 37 °C in 5% CO2 atmosphere Sanyo, Japan) in DMEM medium (Biolot, St. Petersburg, Russia) supplemented with 10 wt.% FBS (HiClone, Logan, UT, USA) and 5 wt.% penicillin–streptomycin (Biolot, St. Petersburg, Russia). Cell viability was determined using trypan blue dye. Cell counting was performed using an automatic cell counter TC20 (Bio-Rad, Hercules, CA, USA). Cells (70,000 cells per well) were cultured in 24-well plates for 24 h in the presence of coating samples. A polystyrene tissue culture plastic plate was used as the control. After incubation, cells were washed with Dulbecco’s Phosphate-Buffered Saline (Biolot, St. Petersburg, Russia) and harvested with trypsin–EDTA, and the viability was analyzed by flow cytometry using the FITC Annexin V Apoptosis Detection Kit with 7-AAD (BioLegend, San Diego, CA, USA) in a Cytoflex flow cytometer (Beckman Coulter, Brea, CA, USA). Fluorescein isothiocyanate (FITC)-labeled annexin V is a calcium-dependent phospholipid-binding protein with a high affinity for phosphatidylserine. Therefore, it can be used as a sensitive probe for the presence of phosphatidylserine on the cell membrane and hence as a marker of apoptosis. Results were processed automatically using CytExpert 2.0 software. Parametric methods were used for statistical processing of the results at a significance level of p ≤ 0.05.
3. Results
3.1. Preparation and Physicochemical Characteristics of ZnO-Ag NPs
According to the phase diagrams of binary systems, the metals Ag and Zn dissolve in each other unrestrictedly in an inert atmosphere. However, the thermodynamic properties of the components of the Zn-Ag-O ternary system are not sufficiently considered in the literature, especially at EETWs above 2000 °C.
The morphology of ZnO-Ag NPs was investigated by transmission electron microscopy (TEM) and high-resolution TEM. The obtained micrographs are shown in Figure 3.

Figure 3.
TEM image (a) and high-resolution TEM image (b) of ZnO-Ag NPs.
The TEM images of the NPs show that they have a predominantly faceted shape and size up to 100 nm (Figure 3a). NPs have the morphology of so-called “Janus-like” nanoparticles, with a clear interface inside the nanoparticle (Figure 3a). As shown by the TEM image elemental mapping analysis (Figure 3b), silver is represented by dark, smaller, rounded areas, and zinc oxide is represented by light, larger fragments of an angular shape.
The following mechanism of EETWs formation of ZnO-Ag “Janus-like” particles can be assumed. With EETWs, when the temperature exceeds the melting points of the metals, Ag and Zn can indefinitely dissolve in each other in an inert atmosphere. In an oxygen-containing atmosphere, the formation of nanoparticles can occur simultaneously with zinc oxidation. Zinc oxide (ZnO) crystallizes at 1975 °C, and silver, with a lower melting point (962 °C), is displaced from the volume of the formed particle, resulting in separation of the components and the formation of a “Janus-like” structure.
According to XRD analysis (Figure 4a), only ZnO (JCPDS No. 96-900-4179) and Ag (JCPDS No. 65-2871) phases are present in NPs; no others were observed. The average size of the silver and zinc oxide crystallites calculated by the Williamson–Hall method was 35 ± 3 nm and 78 ± 2, respectively. The size distribution of the NPs obtained from TEM data by processing 2600 particles is shown in Figure 4b. The particle size distribution was log-normal, and the average particle size was 76 nm.

Figure 4.
XRD diffractogram (a) and particle size distribution (b) of the ZnO-Ag NPs.
The chemical composition of the samples surface was investigated using X-ray photoelectron spectroscopy. Figure 5 shows the Ag3d (Figure 5a) and Zn2p (Figure 5b) spectra of the sample under study.

Figure 5.
XPS spectra of Ag3d (a) and Zn2p (b) of ZnO-Ag nanoparticles. All spectra were normalized by the integral intensity of the peaks corresponding to the metals included in the NPs.
The spectrum of Ag3d is known to be a doublet Ag3d5/2-Ag3d3/2, the integrated intensities of the components which are in a ratio of 3:2. The magnitude of the spin–orbit splitting (the difference between the binding energy values of Ag3d5/2 and Ag3d3/2) is 6.00 eV. In this case, the Ag3d spectrum is well described by a doublet with Ag3d5/2 binding energy in the region of 368.0−368.3 eV. For Ag3d5/2, the two bond energies for silver in different states vary in a narrow range of 367.5–368.5 eV, which makes it difficult to identify the silver state [30,31,32]. The so-called Auger parameter α, being the sum of Ag3d5/2 binding energy and the kinetic energy of the MNN Auger peak, is usually used for identification. The Auger parameter α for the sample was in the range of 725.8−726.1 eV, which is characteristic of silver in the metallic state. The 2p-level of zinc was split into two sublevels, Zn2p3/2 and Zn2p1/2, due to the spin–orbit interaction. Accordingly, in the spectra of the Zn2p surface, the doublet was Zn2p3/2-Zn2p1/2, with the spin–orbit splitting being 23.1 eV. For zinc oxide, the binding energies of the Zn2p3/2 level were observed to be in the range of 1021.5−1022.0 eV [33,34].
A large number of scientific studies have confirmed the key role of reactive oxygen species (ROS) generation in the biocidal activity mechanism of ZnO-Ag NPs [35]. The ability of ZnO-Ag NPs to generate ROS was determined by the degradation of the model organic pollutants methylene blue (MB) and Congo red (CR) dyes under visible light, which can be easily analyzed by spectrophotometry. The choice of dyes was determined by the type of active species for their photodegradation. According to the data summarized in the review in [36], MB is a cationic dye whose degradation occurs under the action of •O2−, while •OH radicals are required for CR degradation. The NP photocatalytic activity was expressed by the degree of dye degradation D (%). The pseudo-first-order rate constant k (min−1) and the correlation coefficient are given in Table 5.

Table 5.
Kinetic parameters of the dye degradation under visible light.
3.2. Nanoparticle Deagglomeration
One of the main problems in obtaining coatings containing nanoparticles is NP agglomeration. EETWs-synthesized nanoparticles are forming aggregates and agglomerates. NP aggregates are easily destroyed by ultrasonic treatment. A particle size study by the sedimentation method using disk centrifuge showed a bimodal NP size distribution, with the maxima of the two peaks being at 50–100 nm and 100−200 nm (Figure 6).

Figure 6.
ZnO-Ag NP agglomerate size distribution.
Considering the particle size distribution (Figure 4), based on the TEM image analysis results, the first peak of the NP and NP agglomerate size distribution (Figure 6, red bars) at 0.05–0.1 nm seems to show NPs and the second peak at 0.1–0.2 nm shows both NP and agglomerate size. The ability to form agglomerates is determined by the surface energy of the nanoparticles (size factor) and the melting temperature of the metal. Silver nanoparticles formed solid agglomerates, which was confirmed by the sedimentation analysis data. The agglomeration of nanoparticles leads to a decrease in antibacterial activity [37]. Ultrasonic treatment for 12 min reduced the amount of nanoparticle agglomerates of 100–200 and 200–500 nm (Figure 7). At the same time, the number of particles in the 50–100 nm fractions increased. A further increase in the ultrasonic treatment time caused the local heating of NP suspension and sintering of NPs.

Figure 7.
Dependence of the number of NPs (50−100 nm fraction) and NP agglomerates (100–200 nm and 200–500 nm fractions) on the time of ultrasonic treatment.
3.3. Characterization of Modified Paint Coating
Nanoparticle suspension was treated with ultrasound for 12 min and mixed with paint using a homogenizer. As a result, modified paint coatings containing 0.1 wt.%−5 wt.% nanoparticles were obtained. The results of the quantitative analysis of the roughness of the modified paint coating showed that the smoothest coating was formed at a particle concentration of 0.1 wt.%. For modified coatings with a mass fraction of particles of 0.1 wt.%; 0.5 wt.%; 1.0 wt.%; 2.0 wt.%; and 5.0 wt.%, the roughness was 28.56 nm; 37.93 nm; 39.4 nm; 41.06 nm; and 45.47 nm, respectively, and was well linearized with a correlation coefficient of 0.95. The intrinsic topography of the coating surface without nanoparticles was 27.8 nm.
The uniformity of the distribution of ZnO-Ag NPs in waterborne acrylic paint and elemental analysis of the prepared paint coating were examined by TEM and SEM. The typical TEM image of the thin-film coating is shown in Figure 8. The coating contains rounded particles of 0.2–0.5 µm and nanoparticles of up to 100 nm. According to energy-dispersive (EDX) analysis, the following elements are present: C, O, Al, Si, Ca, Ti, Zn, and Ag. The ZnO-Ag NPs agglomerates are arranged on the surface of the particles and are marked in Figure 8 with red arrows.

Figure 8.
TEM image of MP(1.0)-modified paint coating and EDX mapping showing element distribution in coating. The nanoparticles are indicated by red arrows.
According to EDX analysis, silver was not always linked to Zn in the NPs in the modified paint coating. This can be attributed to silver migration and changes in nanoparticle morphology due to high-speed dispersion or to the difficulty of examining the coating by TEM.
As seen in Figure 9, the ZnO-Ag particles were uniformly distributed throughout the sample at lower magnification. The coating contained hollow spherical particles of about 0.5 µm, rounded particles of 0.2–0.5 µm, plates of 0.2–5 µm, and nanoparticles of up to 100 nm (Figure 9a). The content of ZnO-Ag particles, determined by SEM (Figure 9b,c), practically corresponded to that input in the paint (1.0 wt.%).

Figure 9.
TEM (a) and SEM (b) images of MP(1.0)-modified paint coating and diagram of element distribution in coating (c).
3.4. Biological Studies of Modified Paint Coating
The antibacterial activity of NP-modified paint coating samples in vitro was evaluated by reducing the number of bacteria on the painted surface during a certain exposure time. The paint without NPs was used as a control. Table 6 summarizes the bacterial counts and bacterial reduction (R), in percent, relative to the negative control after 6 hours of exposure. Data from the R, %, trials for each bacteria strain indicated that the relative average reduction efficiency followed the order of E. coli (99.41% and more) > P. aeruginosa (99.26% and more) > MRSA (98.72% and more) > S. aureus (97.41% and more). The coatings were effective against both types of bacteria; therefore, the gram reaction did not appear to be an indicator of effects. The size and shape of the bacteria cells did not appear to determine the antibacterial effect of the coatings either.

Table 6.
Antibacterial activity of the tested samples, expressed as a decrease in the number of bacteria, in %, relative to the negative control after 6 h of exposure.
Thus, the modified paint coating showed high antibacterial activity against all the tested bacteria already after 6 hours of exposure. The results also showed that the antibacterial activity did not increase significantly during 24 h of incubation. This observation is probably a result of the fact that the surface area of the NPs coming into contact with the bacteria remains unchanged.
The antifungal activity of the modified paint coating samples was investigated against C. albicans fungi. As shown (Figure 10), the MP(2.0) and MP(5.0) samples completely inhibited fungal growth in contrast to the paint without ZnO-Ag NPs. The antifungal effect of ZnO NPs on C. albicans has been reported previously [38,39]. These authors also observed a gradual decrease in the number of viable cells as the concentration of ZnO NPs increased.
Figure 10.
Petri dish photos with C. albicans after incubation on paint and modified paint coating sample surfaces.
The results of the examination performed showed that the NP-modified paint coating, which contains, by weight, 1.0% NPs (MP1.0), completely inactivates the virus, while the sample of commercial paint without NPs reduces the virus by 1.5 log(10) (Table 7).

Table 7.
Antiviral activity measured by a decrease in the content of the smallpox vaccine virus after 2 h of incubation.
Thus, the studied paint samples had different degrees of virucidal activity against smallpox virus. The NP-modified paint coating, which contains 1.0−5.0 wt.% ZnO-Ag NPs, completely inactivated the virus, while the sample of commercial paint without NPs reduced the virus only by 1.5 lg.
To verify that the modified coating produced in this work is low toxicity, we performed flow cytometry studies using the 3T3 fibroblasts cell line. The results of the flow cytometry studies are shown in Figure 11. The percentage of apoptotic cells was 2.41% for the control and 6.80% for the coating, respectively. The percentage of viable cells was >90%, which indicated low toxicity of the modified samples.

Figure 11.
Analysis of the apoptosis of fibroblast 3T3 cell line cultured on tissue culture plastic (a) and coating sample (b) by flow cytometry.
4. Discussion
The use of the EETWs method for the production of heterophase NPs is due to a number of advantages, such as the high purity of the obtained nanopowders, which were sufficiently high throughput. The high chemical purity of the obtained nanoparticles is determined by the purity of the used metal wires, and the electrical explosion conditions exclude the presence of impurities at the interfaces. As a result, heterophase “Janus-like” ZnO-Ag NPs with an Ag content of 15 wt.% were obtained by the EETWs method in oxygen-containing atmosphere. The silver mass ratio was determined by EDX-TEM analysis and corresponded to the silver mass fraction in twisted wires at synthesis. According to XPS analysis, the surface of the ZnO-Ag NPs was enriched with Zn2+ and Ag0. The presence of nanosized metallic silver on the NP surface seriously affected mitochondrial electron transport, phagocytosis, autophagy, organelle integrity, and organization [40]. Bacterial proteins and enzymes can be denatured, aggregated, or inhibited by AgNPs [41]. In addition, Ag has been shown to inactivate both Gram-positive and Gram-negative bacteria. The accumulation of positively charged Zn2+ cation on the surface of NPs causes cell membrane surface dysfunction, which ultimately leads to microbial cell death [42]. The mechanism of the antimicrobial activity of ZnO-Ag NPs is based on their ability to induce the release of reactive oxygen species (ROS), disrupting the function of proteins and DNA and destroying bacterial cell membranes.
The ability of nanoparticles to induce the generation of reactive oxygen species (ROS) is one of the main mechanisms of the antibacterial activity of semiconductor NPs. ROS are a specific set of molecules which include the following: superoxide anion •O2−, peroxide radical •HO2−, and hydroxyl radical •OH, which is the most reactive. In addition, singlet oxygen (1O2), peroxide anion (O22−), and hydroxide ion (OH−) can be produced when NPs interact with bacteria [43]. The generation of ROS causes lipid peroxidation, protein degradation or modification, disruption of bacterial membrane integrity, enzyme degradation, and damage to ribonucleic acid, leading to cell death. The ability of ZnO-Ag NPs to generate ROS was determined by the degradation of model organic pollutants MB and CR dyes under visible light. As can be seen from the presented data, ZnO-Ag NPs demonstrated high photodegradation efficiency for both dyes. After 60 min of irradiation, the dyes degraded almost completely (99.5% for MB and 99.7% for CR). Such high activity is due to the effective charge separation in heterophase ZnO-Ag NPs relative to sole ZnO and Ag [44]. The synergistic photocatalytic activity of the ZnO-Ag structure is well known [45]. The deposition of Ag on ZnO in the form of nanoparticles has been shown to generate a large number of •OH radicals [24], which are the main oxidizing agents inhibiting the growth of E. coli bacteria. The oxidation of lipids in E. coli cells is triggered by their interaction with ROS, such as singlet oxygen and hydroxyl radicals •OH and H2O2 [46]. In the present study, synthesized ZnO-Ag NPs were able to generate ROS. Thus, the high activity of NPs in dye photodegradation was expected to correlate with their antimicrobial activity in NP-modified paint.
The study of the antimicrobial effect of the modified paint coating containing ZnO-Ag nanoparticles showed that this paint has significant antibacterial, antifungal, and virucidal activities. The high activity of the ZnO/Ag NPs obtained with the EETWs method can be explained by the tight contact at the interface between the phases of ZnO and Ag, formed under conditions of simultaneous EETWs in the atmosphere of argon + oxygen. Such conditions, unlike chemical precipitation, exclude the presence of impurities at the interface. Since the energy of the ZnO conduction band is higher than the Fermi level for Ag, electrons can transfer from ZnO to Ag nanoparticles. Consequently, Ag nanoparticles can capture photoinduced electrons, preventing their recombination. Electrons accumulated on silver can be transferred to oxygen molecules adsorbed on the surface, with the formation of radicals •HO2 and •OH. Photoinduced holes are capable of reacting with surface-bound H2O or OH-forming hydroxyl radicals, which are strong oxidizing agents for organic chemicals and microorganisms. A large number of articles have demonstrated the antibacterial activity of ZnO-Ag NPs [47,48,49,50]. Aptly, the Ag islands (3 wt.% and 5 wt.%) on ZnO NPs showed synergetic enhanced antibacterial activity in our study [51]. The ZnO and Ag combination enhanced biocide action, leading to an extremely fast total suppression of E. coli within a few minutes, while S. aureus required some hours to suppress, due to the dissimilar bacterial walls [52]. The Ag/ZnO nanorods acted primarily through direct contact, resulting in the killing of bacteria [53].
Tornero et al. [9] investigated the antimicrobial activity of ZnO NPs coated with Ag NPs obtained by the flame spray pyrolysis process in water-based paints. ZnO-Ag NPs at contents of 0.15% and 0.30% inhibited the growth of various bacteria, including P. aeruginosa, S. senftenberg, B. subtilis, and Listeria monocytogenes, and mold fungi, including Aspergillus niger. However, the maximum reduction in bacterial counts reached only 84% (for L. monocytogenes). The authors also observed a decrease in the antimicrobial effect during the aging and leaching of the paint. The authors [54] treated the water-based paint with ZnO/clay nanocomposite containing ZnO NPs 56 nm in size. The antifungal activity of the inorganic composite was tested against common A. niger fungi. The addition of ZnO NPs at an amount of 0.5 wt.% enhanced the antifungal properties of the modified clay.
Viruses, given the severity of the diseases they cause, have always been considered high-risk factors. Due to the World Health Organization’s recommendation to stop the widespread vaccination against smallpox in all countries after its eradication, humans have lost immunity to smallpox, meaning that it can now be used in bioterrorist attacks [55,56]. This has led to the fact that, at present, the vast majority of people are not immune not only to smallpox but also to human infections caused by viruses closely related to smallpox. In 2022, this caused the spread of monkeypox virus beyond its endemic territories, penetrating into various territories of Europe and North America [57]. The virucidal activity of ZnO-Ag-containing paints against smallpox virus is shown for the first time in our study. The virucidal activity of coatings containing silver, copper oxide, or zinc oxide nanoparticles against SARS-CoV-2 has previously been comparatively evaluated in [58]. Nanosilver particles as a coating exhibited the strongest antiviral activity of the three studied nanomaterials, while copper oxide exhibited moderate activity, and zinc oxide did not appear to significantly reduce virus infectivity. The results obtained of the authors in [59] provide evidence that paint layers containing galvanic microcells of zinc and copper with a total copper surface area of 4.4% display virucidal activity according to ISO 21702 standard with human coronavirus NL63 as a model organism. In [60], antimicrobial coatings were developed from pure ZnO particles that reduce the infectivity of SARS-CoV-2 suspensions by >99.9% in 1 h. The study in [61] evaluates the high virucidal activity of acrylic paint surfaces painted with nanostructured ZnO–aloe pigments with a 10 wt.%. ZnO mass ratio against SARS-CoV-2. Compared to the previous examples, heterophase ZnO-Ag NPs completely inactivate the virus at a concentration in paint of 1.0 wt%. Our study suggest that ZnO-Ag NPs produced by the EETWs method may act as effective antiviral agents against current and future viruses, fungi, and bacteria, including antibiotic-resistant strains. The synergetic effect of the Janus-like structure of nanoparticles has led to the more effective suppression of the growth of microorganisms and reduced the concentration of active substances and, accordingly, their toxicity.
5. Conclusions
In present time, surfaces capable of inactivating pathogens are urgently needed. The aim of this study was to investigate for the first time the antimicrobial activity of electrical explosive heterophase ZnO-Ag NPs fixed with adequate homogeneity in water-based acrylic paint layers. It has been experimentally proven that the paint coating with a ZnO-Ag nanoparticle mass ratio of 1.0 wt.% displays significant antibacterial activity (more than 99% reduction) and 100% antifungal activity. These results suggest that ZnO-Ag NPs can be used as an effective antibacterial and antifungal agent in water-based paints in several areas (food safety, hospitals, schools, etc.). In addition, this coating inactivates > 99% of viruses after 2 h of contact time, which is standard relative to a nontreated control according to ISO 21702. But, it is necessary to test each virus category, such as enveloped or nonenveloped; DNA-based or RNA-based. The productivity of electric explosive technology (productivity of one setup is about 200 g/h) allows for the organization of the large-scale production of ZnO-Ag nanoparticles. We anticipate that the technology presented here could be used by paint manufacturers for surface coating modifications to reduce the spread of infectious diseases via surfaces.
Author Contributions
Conceptualization, O.B., E.P. and M.L.; methodology, O.B., T.P. and A.P.; software, A.V.; validation, E.E. and A.A.; investigation, O.B., E.P., L.S. and T.P.; resources, E.E. and N.Y.; data curation, E.P.; writing—original draft preparation, O.B. and A.A.; writing—review and editing, M.L., A.P., L.S. and A.V.; visualization, O.B.; supervision, A.V.; project administration, M.L.; funding acquisition, N.Y. All authors have read and agreed to the published version of the manuscript.
Funding
This research was funded by the Ministry of Science and Higher Education of the Russian Federation, Agreement No. 075-11-2021-036 dated 25 June 2021.
Institutional Review Board Statement
Not applicable.
Informed Consent Statement
Not applicable.
Data Availability Statement
The data that support the findings of this study are available on request from the corresponding author, Olga Bakina, ovbakina@ispms.ru.
Conflicts of Interest
The authors declare no conflicts of interest.
References
- Johnson, J.A. Nosocomial Infections. In Critical Care; Routledge: Abingdon, UK, 2021; pp. 82–83. [Google Scholar]
- Frei, A.; Verderosa, A.D.; Elliott, A.G.; Zuegg, J.; Blaskovich, M.A. Metals to combat antimicrobial resistance. Nat. Rev. Chem. 2023, 7, 202–224. [Google Scholar] [CrossRef]
- Cong, W.; Poudel, A.N.; Alhusein, N.; Wang, H.; Yao, G.; Lambert, H. Antimicrobial use in COVID-19 patients in the first phase of the SARS-CoV-2 pandemic: A scoping review. Antibiotics 2021, 10, 745. [Google Scholar] [CrossRef] [PubMed]
- Zhang, S.; Lu, J.; Wang, Y.; Verstraete, W.; Yuan, Z.; Guo, J. Insights of metallic nanoparticles and ions in accelerating the bacterial uptake of antibiotic resistance genes. J. Hazard. Mater. 2022, 421, 126728. [Google Scholar] [CrossRef] [PubMed]
- Mallakpour, S.; Hussain, C.M.; Abdukhakimov, M.; Khaydarov, R.; Krishnamurthy, P.T.; Evgrafova, S. Silver-Nanoparticle-Embedded Antimicrobial Paints. In Handbook of Consumer Nanoproducts; Springer: Berlin/Heidelberg, Germany, 2021; pp. 1–10. [Google Scholar]
- Nemeş, N.S.; Ardean, C.; Davidescu, C.M.; Negrea, A.; Ciopec, M.; Duţeanu, N.; Muntean, D. Antimicrobial activity of cellulose based materials. Polymers 2022, 14, 735. [Google Scholar] [CrossRef] [PubMed]
- Chakraborty, N.; Jha, D.; Roy, I.; Kumar, P.; Gaurav, S.S.; Marimuthu, K.; Gautam, H.K. Nanobiotics against antimicrobial resistance: Harnessing the power of nanoscale materials and technologies. J. Nanobiotechnol. 2022, 20, 375. [Google Scholar] [CrossRef]
- Mohite, V.S.; Darade, M.M.; Sharma, R.K.; Pawar, S.H. Nanoparticle engineered photocatalytic paints: A roadmap to self-sterilizing against the spread of communicable diseases. Catalysts 2022, 12, 326. [Google Scholar] [CrossRef]
- Tornero, A.C.F.; Blasco, M.G.; Azqueta, M.C. Antimicrobial ecological waterborne paint based on novel hybrid nanoparticles of zinc oxide partially coated with silver. Prog. Org. Coat. 2018, 121, 130–141. [Google Scholar] [CrossRef]
- Yazid, S.A.; Mohd, Z.; Mohamad, J. Effect of titanium (IV) isopropoxide molarity on the crystallinity and photocatalytic activity of titanium dioxide thin film deposited via green sol-gel route. J. Mater. Res. Technol. 2018, 8, 1434–1439. [Google Scholar] [CrossRef]
- Slavin, Y.N.; Asnis, J.; Hńfeli, U.O.; Bach, H. Metal nanoparticles: Understanding the mechanisms behind antibacterial activity. J. Nanobiotechnol. 2017, 15, 65. [Google Scholar] [CrossRef]
- Bolaina-Lorenzo, E.; Puente-Urbina, B.A.; Espinosa-Neira, R.; Ledezma, A.; Rodríguez-Fernández, O.; Betancourt-Galindo, R. A simple method to improve antibacterial properties in commercial face masks via incorporation of ZnO and CuO nanoparticles through chitosan matrix. Mater. Chem. Phys. 2022, 287, 126299. [Google Scholar] [CrossRef]
- Pulit-Prociak, J.; Chwastowski, J.; Kucharski, A.; Banach, M. Functionalization of textiles with silver and zinc oxide nanoparticles. Appl. Surf. Sci. 2016, 385, 543–553. [Google Scholar] [CrossRef]
- Gudkov, S.V.; Burmistrov, D.E.; Serov, D.A.; Rebezov, M.B.; Semenova, A.A.; Lisitsyn, A.B. A mini review of antibacterial properties of ZnO nanoparticles. Front. Phys. 2021, 9, 641481. [Google Scholar] [CrossRef]
- Mishra, Y.K.; Adelung, R.; Röhl, C.; Shukla, D.; Spors, F.; Tiwari, V. Virostatic Potential of Micro-Nano Filopodia-Like ZnO Structures against Herpes Simplex Virus-1. Antivir. Res. 2011, 92, 305–312. [Google Scholar] [CrossRef] [PubMed]
- Gupta, J.; Irfan, M.; Ramgir, N.; Muthe, K.P.; Debnath, A.K.; Ansari, S.; Surjit, M. Antiviral activity of zinc oxide nanoparticles and tetrapods against the Hepatitis E and Hepatitis C viruses. Front. Microbiol. 2022, 13, 881595. [Google Scholar] [CrossRef] [PubMed]
- Melk, M.M.; El-Hawary, S.S.; Melek, F.R.; Saleh, D.O.; Ali, O.M.; El Raey, M.A.; Selim, N.M. Antiviral activity of zinc oxide nanoparticles mediated by Plumbago indica L. extract against Herpes Simplex Virus Type 1 (HSV-1). Int. J. Nanomed. 2021, 16, 8221–8233. [Google Scholar] [CrossRef] [PubMed]
- Wolfgruber, S.; Rieger, J.; Cardozo, O.; Punz, B.; Himly, M.; Stingl, A.; Zatloukal, K. Antiviral Activity of Zinc Oxide Nanoparticles against SARS-CoV-2. Int. J. Mol. Sci. 2023, 24, 8425. [Google Scholar] [CrossRef]
- Hassan, H.S.; Abol-Fotouh, D.; Salama, E.; Elkady, M.F. Assessment of antimicrobial, cytotoxicity, and antiviral impact of a green zinc oxide/activated carbon nanocomposite. Sci. Rep. 2022, 12, 8774. [Google Scholar] [CrossRef]
- Mohd Yusof, H.; Mohamad, R.; Zaidan, U.H.; Abdul Rahman, N.A. Microbial synthesis of zinc oxide nanoparticles and their potential application as an antimicrobial agent and a feed supplement in animal industry: A review. J. Anim. Sci. Biotechnol. 2019, 10, 57. [Google Scholar] [CrossRef]
- Zudyte, B.; Luksiene, Z. Visible light-activated ZnO nanoparticles for microbial control of wheat crop. J. Photochem. Photobiol. B Biol. 2021, 219, 112206. [Google Scholar] [CrossRef] [PubMed]
- Hong, D.; Cao, G.; Qu, J.; Deng, Y.; Tang, J. Antibacterial activity of Cu2O and Ag co-modified rice grains-like ZnO nanocomposites. J. Mater. Sci. Technol. 2018, 34, 2359–2367. [Google Scholar] [CrossRef]
- Vikal, S.; Gautam, Y.K.; Ambedkar, A.K.; Gautam, D.; Singh, J.; Pratap, D.; Singh, B.P. Structural, optical and antimicrobial properties of pure and Ag-doped ZnO nanostructures. J. Semicond. 2022, 43, 032802. [Google Scholar] [CrossRef]
- Chauhan, A.; Verma, R.; Kumari, S.; Sharma, A.; Shandilya, P.; Li, X.; Kumar, R. Photocatalytic dye degradation and antimicrobial activities of Pure and Ag-doped ZnO using Cannabis sativa leaf extract. Sci. Rep. 2020, 10, 7881. [Google Scholar] [CrossRef]
- Pathak, T.K.; Kroon, R.E.; Craciun, V.; Popa, M.; Chifiriuc, M.C.; Swart, H. Influence of Ag, Au and Pd noble metals doping on structural, optical and antimicrobial properties of zinc oxide and titanium dioxide nanomaterials. Heliyon 2019, 5, e01333. [Google Scholar] [CrossRef]
- Bakina, O.V.; Glazkova, E.A.; Pervikov, A.V.; Rodkevich, N.G.; Vornakova, E.A.; Chzhou, V.R.; Lerner, M.I. Electric explosion of wires as versatile method for antibacterial Janus-like ZnO–Ag nanoparticles preparation. J. Mater. Sci. Mater. Electron. 2021, 32, 10623–10634. [Google Scholar] [CrossRef]
- Lozhkomoev, A.S.; Kazantsev, S.O.; Kondranova, A.M.; Fomenko, A.N.; Pervikov, A.V.; Rodkevich, N.G.; Bakina, O.V. Design of antimicrobial composite nanoparticles ZnxMe (100-x)/O by electrical explosion of two wires in the oxygen-containing atmosphere. Mater. Des. 2019, 183, 108099. [Google Scholar] [CrossRef]
- ISO 21702; Measurement of Antiviral Activity on Plastics and Other Non-Porous Surfaces. ISO: Geneva, Switzerland, 2019.
- ISO 22196; Measurement of Antibacterial Activity on Plastics and Other Non-Porous Surfaces. ISO: Geneva, Switzerland, 2011.
- Lamb, R.N.; Ngamsom, B.; Trimm, D.L.; Gong, B.; Silveston, P.L.; Praserthdam, P. Surface characterisation of Pd–Ag/Al2O3 catalysts for acetylene hydrogenation using an improved XPS procedure. Appl. Catal. A Gen. 2004, 268, 43–50. [Google Scholar] [CrossRef]
- Kaushik, V.K. XPS core level spectra and Auger parameters for some silver compounds. J. Electron Spectrosc. Relat. Phenom. 1991, 56, 273–277. [Google Scholar] [CrossRef]
- Bukhtiyarov, A.V.; Stakheev, A.Y.; Mytareva, A.I.; Prosvirin, I.P.; Bukhtiyarov, V.I. In situ XPS study of the size effect in the interaction of NO with the surface of the model Ag/Al2O3/FeCrAl catalysts. Russ. Chem. Bull. 2015, 64, 2780–2785. [Google Scholar] [CrossRef]
- Wang, H.; Luo, S.; Li, X.; Liu, W.; Wu, X.; Weng, D.; Liu, S. Thermally stable Ag/Al2O3 confined catalysts with high diffusion-induced oxidation activity. Catal. Today 2019, 332, 189–194. [Google Scholar] [CrossRef]
- Claros, M.; Setka, M.; Jimenez, Y.P.; Vallejos, S. AACVD synthesis and characterization of iron and copper oxides modified ZnO structured films. Nanomaterials 2020, 10, 471. [Google Scholar] [CrossRef] [PubMed]
- Abebe, B.; Zereffa, E.A.; Tadesse, A.; Murthy, H.A. A review on enhancing the antibacterial activity of ZnO: Mechanisms and microscopic investigation. Nanoscale Res. Lett. 2020, 15, 190. [Google Scholar] [CrossRef]
- Neykova, N.; Stuchlik, J.; Hruska, K.; Poruba, A.; Remes, Z.; Pop-Georgievski, O. Study of the surface properties of ZnO nanocolumns used for thin-film solar cells. Beilstein J. Nanotechnol. 2017, 8, 446–451. [Google Scholar] [CrossRef] [PubMed]
- Holubnycha, V.; Myronov, P.; Bugaiov, V.; Opanasyuk, A.; Dobrozhan, O.; Yanovska, A.; Pogorielov, M.; Kalinkevichet, O. Effect of ultrasound treatment on chitosan-silver nanoparticles antimicrobial activity. In Proceedings of the IEEE 8th International Conference Nanomaterials: Application & Properties (NAP), Zatoka, Ukraine, 9–14 September 2018; pp. 1–4. [Google Scholar]
- Sharma, R.K.; Ghose, R. Synthesis of zinc oxide nanoparticles by homogeneous precipitation method and its application in antifungal activity against Candida albicans. Ceram. Int. 2015, 41, 967–975. [Google Scholar] [CrossRef]
- Djearamane, S.; Xiu, L.J.; Wong, L.S.; Rajamani, R.; Bharathi, D.; Kayarohanam, S.; Selvaraj, S. Antifungal Properties of Zinc Oxide Nanoparticles on Candida albicans. Coatings 2022, 12, 1864. [Google Scholar] [CrossRef]
- Crisan, C.M.; Mocan, T.; Manolea, M.; Lasca, L.I.; Tăbăran, F.A.; Mocan, L. Review on silver nanoparticles as a novel class of antibacterial solutions. Appl. Sci. 2021, 11, 1120. [Google Scholar] [CrossRef]
- Adnan, M.; Siddiqui, A.J.; Ashraf, S.A.; Ashraf, M.S.; Alomrani, S.O.; Alreshidi, M.; Patel, M. Saponin-Derived Silver Nanoparticles from Phoenix dactylifera (Ajwa Dates) Exhibit Broad-Spectrum Bioactivities Combating Bacterial Infections. Antibiotics 2023, 12, 1415. [Google Scholar] [CrossRef]
- Nisar, P.; Ali, N.; Rahman, L.; Ali, M.; Shinwari, Z.K. Antimicrobial activities of biologically synthesized metal nanoparticles: An insight into the mechanism of action. JBIC J. Biol. Inorg. Chem. 2019, 24, 929–941. [Google Scholar] [CrossRef] [PubMed]
- Dunnill, C.; Patton, T.; Brennan, J.; Barrett, J.; Dryden, M.; Cooke, J.; Georgopoulos, N.T. Reactive oxygen species (ROS) and wound healing: The functional role of ROS and emerging ROS-modulating technologies for augmentation of the healing process. Int. Wound J. 2017, 14, 89–96. [Google Scholar] [CrossRef]
- Karagoz, S.; Kiremitler, N.B.; Sarp, G.; Pekdemir, S.; Salem, S.; Goksu, A.G.; Yilmaz, E. Antibacterial, antiviral, and self-cleaning mats with sensing capabilities based on electrospun nanofibers decorated with ZnO nanorods and Ag nanoparticles for protective clothing applications. ACS Appl. Mater. Interfaces 2021, 13, 5678–5690. [Google Scholar] [CrossRef]
- Kandula, S.; Jeevanandam, P. Sun-Light-Driven Photocatalytic Activity by ZnO/Ag Heteronanostructures Synthesized via a Facile Thermal Decomposition Approach. RSC Adv. 2015, 5, 76150–76159. [Google Scholar] [CrossRef]
- Rokesh, K.; Mohan, S.C.; Karuppuchamy, S.; Jothivenkatachalam, K. Photo-assisted advanced oxidation processes for Rhodamine B degradation using ZnO–Ag nanocomposite materials. J. Environ. Chem. Eng. 2018, 6, 3610–3620. [Google Scholar] [CrossRef]
- Mohapatra, B.; Mohapatra, S.; Sharma, N. Biosynthesized Ag–ZnO nanohybrids exhibit strong antibacterial activity by inducing oxidative stress. Ceram. Int. 2023, 49, 20218–20233. [Google Scholar] [CrossRef]
- Shang, J.; Sun, Y.; Zhang, T.; Liu, Z.; Zhang, H. Enhanced antibacterial activity of Ag nanoparticle-decorated ZnO nanorod arrays. J. Nanomater. 2019, 2019, 3281802. [Google Scholar] [CrossRef]
- Zhao, Y.; Li, S.; Zeng, Y.; Jiang, Y. Synthesis and properties of Ag/ZnO core/shell nanostructures prepared by excimer laser ablation in liquid. APL Mater. 2015, 3, 086103. [Google Scholar] [CrossRef]
- Naskar, A.; Lee, S.; Kim, K.S. Easy one-pot low-temperature synthesized Ag-ZnO nanoparticles and their activity against clinical isolates of methicillin-resistant Staphylococcus aureus. Front. Bioeng. Biotechnol. 2020, 8, 216. [Google Scholar] [CrossRef]
- Zhang, Y.; Gao, X.; Zhi, L.; Liu, X.; Jiang, W.; Sun, Y.; Yang, J. The synergetic antibacterial activity of Ag islands on ZnO (Ag/ZnO) heterostructure nanoparticles and its mode of action. J. Inorg. Biochem. 2014, 130, 74–83. [Google Scholar] [CrossRef]
- Valerini, D.; Tammaro, L.; Vigliotta, G.; Picariello, E.; Banfi, F.; Cavaliere, E.; Gavioli, L. Ag functionalization of Al-doped ZnO nanostructured coatings on PLA substrate for antibacterial applications. Coatings 2020, 10, 1238. [Google Scholar] [CrossRef]
- Agnihotri, S.; Bajaj, G.; Mukherji, S.; Mukherji, S. Arginine-assisted immobilization of silver nanoparticles on ZnO nanorods: An enhanced and reusable antibacterial substrate without human cell cytotoxicity. Nanoscale 2015, 7, 7415–7429. [Google Scholar] [CrossRef]
- de Lucas-Gil, E.; Menendez, J.; Pascual, L.; Fernandez, J.F.; Rubio-Marcos, F. The benefits of the ZnO/clay composite formation as a promising antifungal coating for paint applications. Appl. Sci. 2020, 10, 1322. [Google Scholar] [CrossRef]
- Olson, V.A.; Shchelkunov, S.N. Are we prepared in case of a possible smallpox-like disease emergence? Viruses 2017, 9, 242. [Google Scholar] [CrossRef]
- Fenner, F.; Henderson, D.A.; Arita, I.; Jezek, Z.; Ladnyi, I.D. Smallpox and Its Eradication; World Health Organization: Geneva, Switzerland, 1988; p. 1460. [Google Scholar]
- World Health Organization. 2022–2023 Mpox (Monkeypox) Outbreak: Global Trends; World Health Organization: Geneva, Switzerland, 2023. [Google Scholar]
- Merkl, P.; Long, S.; McInerney, G.M.; Sotiriou, G.A. Antiviral activity of silver, copper oxide and zinc oxide nanoparticle coatings against SARS-CoV-2. Nanomaterials 2021, 11, 1312. [Google Scholar] [CrossRef] [PubMed]
- Spisak, W.; Kaszczyszyn, M.; Szar, M.; Kozak, J.; Stachowicz, K. Antiviral activity of galvanic microcells of zinc and copper contained within painted surfaces. Sci. Rep. 2022, 12, 1368. [Google Scholar] [CrossRef] [PubMed]
- Hosseini, M.; Behzadinasab, S.; Chin, A.W.; Poon, L.L.; Ducker, W.A. Reduction of infectivity of SARS-CoV-2 by zinc oxide coatings. ACS Biomater. Sci. Eng. 2021, 7, 5022–5027. [Google Scholar] [CrossRef]
- Primo, J.D.O.; Correa, J.D.S.; Horsth, D.F.; Das, A.; Zając, M.; Umek, P.; Bittencourt, C. Antiviral Properties against SARS-CoV-2 of Nanostructured ZnO Obtained by Green Combustion Synthesis and Coated in Waterborne Acrylic Coatings. Nanomaterials 2022, 12, 4345. [Google Scholar] [CrossRef] [PubMed]
Disclaimer/Publisher’s Note: The statements, opinions and data contained in all publications are solely those of the individual author(s) and contributor(s) and not of MDPI and/or the editor(s). MDPI and/or the editor(s) disclaim responsibility for any injury to people or property resulting from any ideas, methods, instructions or products referred to in the content. |
© 2024 by the authors. Licensee MDPI, Basel, Switzerland. This article is an open access article distributed under the terms and conditions of the Creative Commons Attribution (CC BY) license (https://creativecommons.org/licenses/by/4.0/).
